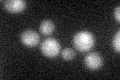
YGR280C
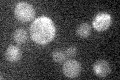
YGR280C

View description
Essential protein involved in rRNA and snoRNA maturation; competes with TLC1 RNA for binding to Est2p, suggesting a role in negative regulation of telomerase; human homolog inhibits telomerase; contains a G-patch RNA interacting domain
Localization:
Intensity:
Fold change:
Significance:
-
C’ GFP library in SD

below threshold15.69 -
N' NOP1pr-GFP in SD

nucleolus101.991 -
N' TEF2pr-mCherry in SD

nucleolus16.4535 -
N' NATIVEpr-GFP in SD

nucleolus45.5623 -
N' TEF2pr-VC and Cyto-VN in SD

nucleolus29.6476 -
C’ GFP library in SD+DTT
cytosolN/AN/ANo -
C’ GFP library in SD+H2O2

cytosolN/AN/ANo -
C’ GFP library in Starvation Media
cytosolN/AN/AYes -
C’ GFP library on the background of Pup2-DaMP

below threshold -
C’ GFP library on the background of CCT mutant

below thresholdN/AN/ANo
